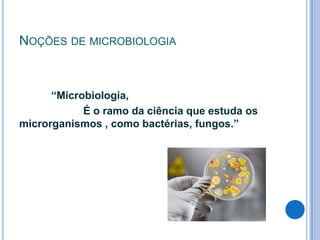
NOÇÕES DE MICROBIOLOGIA

“Microbiologia,
É o ramo da ciência que estuda os
microrganismos , como bactérias, fungos.”

O documento discute biossegurança e gestão de resíduos em serviços de saúde. Aborda conceitos como biossegurança, educação ambiental, relação entre saúde e meio ambiente, classificação e manejo adequado de resíduos hospitalares, noções de microbiologia e controle de infecção hospitalar.